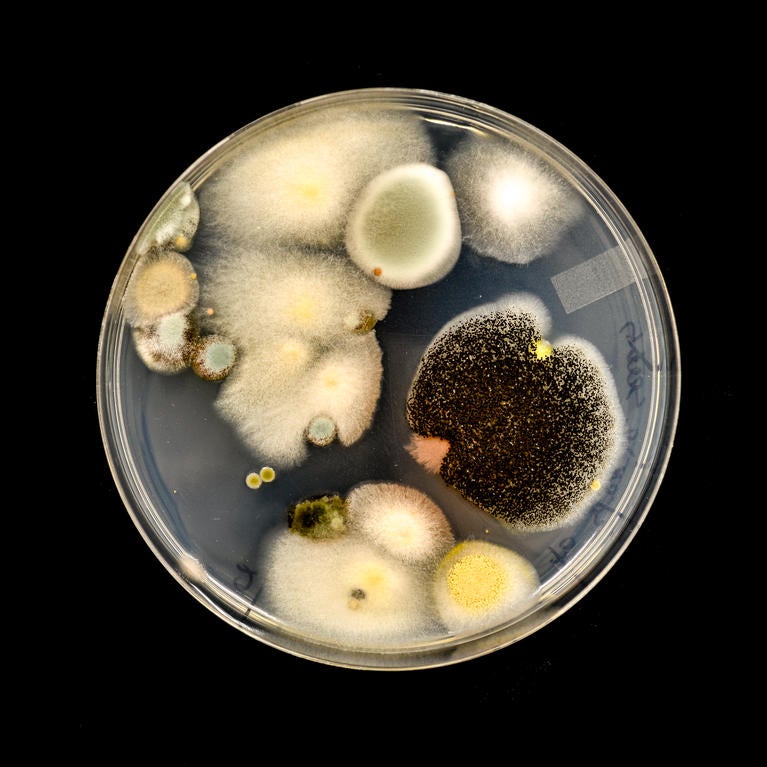
citrus microbiome

Modified yeast inhibits fungal growth in plants
External application could reduce agricultural reliance on fungicides
By Holly Ober |
| Science / Technology
09b9.jpg?h=358c1813&itok=lYXHaK0T)
UCR Herbarium founder donates $900K to preserve its future
UC Riverside’s herbarium, established over 60 years ago, is an irreplaceable library of plant specimens. Now, a $900,000 bequest from its founder Frank Vasek and his wife Maxine will ensure the resource remains available to many generations of future plant scientists, and that it receives needed repairs and reorganization. Vasek...
By Jules Bernstein |
| University

5fb2.jpg?h=7985451d&itok=50xnTJyG)

d2e6.jpg?h=fa5a6c65&itok=xCOvXASD)


2413.jpg?h=35d27844&itok=u8ZP3EuW)



